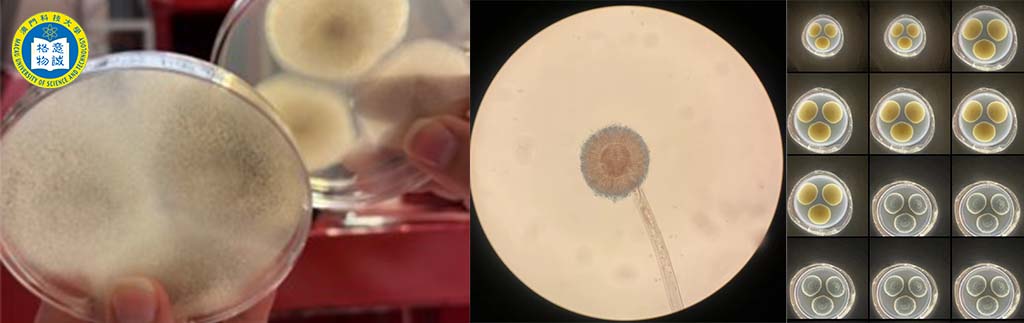

Summary
This paper delves into the mycosynthesis of titanium dioxide (TiO2) nanoparticles (NPs), highlighting the unique attributes and applications of TiO2 NPs and their production methods. It focuses on the mycogenic synthesis of these nanoparticles (using fungi), a technique that remains underutilized but shows significant potential for innovation in nanotechnology. TiO2 plays a highly relevant role in various fields due to its semiconductor properties and ability to induce photocatalysis when exposed to ultraviolet (UV) light, making it an ideal candidate for environmental remediation, solar energy conversion, and antimicrobial applications.
Fungi are versatile microorganisms with inherent capabilities to interact with metal ions and reduce them to form nanoparticles. Despite their promising attributes, the biogenic processes using them to synthesize TiO2 NPs have not been extensively explored. The research underscores the need for further study into fungal diversity and the exploitation of extremophilic fungi from unique environments – such as extreme temperatures, high salinity, or extreme pH, which could yield significant discoveries in nanoparticle synthesis.
The study emphasizes the significant gaps in current knowledge and the potential of fungi as a source for new and sustainable nanoparticle production methods, advocating for increased research and bioprospection in mycology. The fungal kingdom can be a rich source of innovation in nanotechnology.
Simões, M. F. (2023). Mycosynthesis of titanium dioxide (TiO2) nanoparticles and their applications. In Fungal Cell Factories for Sustainable Nanomaterials Productions and Agricultural Applications (pp. 225-255). Elsevier, doi: 10.1016/B978-0-323-99922-9.00004-0.